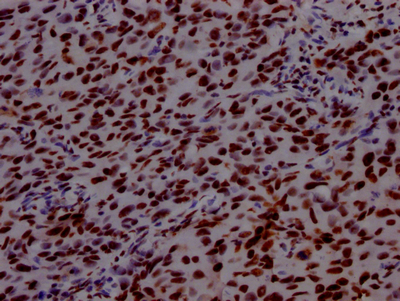

-
中文名稱:PABPN1重組抗體
-
貨號:CSB-RA569290A0HU
-
規格:¥1320
-
圖片:
-
Western Blot
Positive WB detected in: 293 whole cell lysate, MCF-7 whole cell lysate, Raji whole cell lysate, HepG2 whole cell lysate
All lanes: PABPN1 antibody at 1:2000
Secondary
Goat polyclonal to rabbit IgG at 1/50000 dilution
Predicted band size: 33, 32, 38 kDa
Observed band size: 50 kDa -
IHC image of CSB-RA569290A0HU diluted at 1:100 and staining in paraffin-embedded human testis tissue performed on a Leica BondTM system. After dewaxing and hydration, antigen retrieval was mediated by high pressure in a citrate buffer (pH 6.0). Section was blocked with 10% normal goat serum 30min at RT. Then primary antibody (1% BSA) was incubated at 4℃ overnight. The primary is detected by a Goat anti-rabbit IgG polymer labeled by HRP and visualized using 0.05% DAB.
-
IHC image of CSB-RA569290A0HU diluted at 1:100 and staining in paraffin-embedded human bladder cancer performed on a Leica BondTM system. After dewaxing and hydration, antigen retrieval was mediated by high pressure in a citrate buffer (pH 6.0). Section was blocked with 10% normal goat serum 30min at RT. Then primary antibody (1% BSA) was incubated at 4℃ overnight. The primary is detected by a Goat anti-rabbit IgG polymer labeled by HRP and visualized using 0.05% DAB.
-
Immunofluorescence staining of Hela Cells with CSB-RA569290A0HU at 1:50, counter-stained with DAPI. The cells were fixed in 4% formaldehyde, permeated by 0.2% TritonX-100, and blocked in 10% normal Goat Serum. The cells were then incubated with the antibody overnight at 4℃. Nuclear DNA was labeled in blue with DAPI. The secondary antibody was FITC-conjugated AffiniPure Goat Anti-Rabbit IgG (H+L).
-
Overlay histogram showing Hela cells stained with CSB-RA569290A0HU (red line) at 1:50. The cells were fixed with 70% Ethylalcohol (18h) and then incubated in 10% normal goat serum to block non-specific protein-protein interactions followedby the antibody (1μg/1*106 cells) for 1 h at 4℃.The secondary antibody used was FITC-conjugated goat anti-rabbit IgG (H+L) at 1/200 dilution for 30min at 4℃. Control antibody (green line) was Rabbit IgG (1μg/1*106 cells) used under the same conditions. Acquisition of >10,000 events was performed.
-
-
其他:
產品詳情
-
產品描述:CSB-RA569290A0HU PABPN1重組單克隆抗體是針對核內多聚腺苷酸結合蛋白1(PABPN1)開發的高特異性科研試劑。PABPN1是調控mRNA多聚腺苷酸化及核質轉運的關鍵因子,在基因表達調控和RNA代謝中發揮重要作用。本抗體經多種實驗平臺嚴格驗證,適用于ELISA、蛋白質印跡(WB)、免疫組織化學(IHC)、免疫熒光(IF)及流式細胞術(FC)等多種檢測體系,其中WB推薦稀釋比為1:500-1:5000,可清晰識別內源性靶蛋白;IHC在1:50-1:200范圍內能有效顯示組織切片中的抗原定位;IF和FC實驗在1:20-1:200稀釋條件下呈現優異的特異性信號。該產品適用于探究PABPN1在RNA加工、細胞應激響應中的分子機制,也可用于肌肉疾病相關研究模型中的蛋白質表達分析、亞細胞定位示蹤及免疫細胞表型鑒定等科研場景,為分子生物學、細胞生物學及病理機制研究提供可靠工具。所有實驗數據均經陽性和陰性對照驗證,確保結果的準確性和可重復性。
-
Uniprot No.:
-
基因名:PABPN1
-
別名:Polyadenylate-binding protein 2 (PABP-2) (Poly(A)-binding protein 2) (Nuclear poly(A)-binding protein 1) (Poly(A)-binding protein II) (PABII) (Polyadenylate-binding nuclear protein 1), PABPN1, PAB2 PABP2
-
反應種屬:Human
-
免疫原:A synthesized peptide derived from human PABPN1
-
免疫原種屬:Homo sapiens (Human)
-
標記方式:Non-conjugated
-
克隆類型:Monoclonal
-
抗體亞型:Rabbit IgG
-
純化方式:Affinity-chromatography
-
克隆號:6C3
-
濃度:It differs from different batches. Please contact us to confirm it.
-
保存緩沖液:Rabbit IgG in 10mM phosphate buffered saline , pH 7.4, 150mM sodium chloride, 0.05% BSA, 0.02% sodium azide and 50% glycerol.
-
產品提供形式:Liquid
-
應用范圍:ELISA, WB, IHC, IF, FC
-
推薦稀釋比:
Application Recommended Dilution WB 1:500-1:5000 IHC 1:50-1:200 IF 1:20-1:200 FC 1:20-1:200 -
Protocols:
-
儲存條件:Upon receipt, store at -20°C or -80°C. Avoid repeated freeze.
-
貨期:Basically, we can dispatch the products out in 1-3 working days after receiving your orders. Delivery time maybe differs from different purchasing way or location, please kindly consult your local distributors for specific delivery time.
-
用途:For Research Use Only. Not for use in diagnostic or therapeutic procedures.
相關產品
靶點詳情
-
功能:Involved in the 3'-end formation of mRNA precursors (pre-mRNA) by the addition of a poly(A) tail of 200-250 nt to the upstream cleavage product. Stimulates poly(A) polymerase (PAPOLA) conferring processivity on the poly(A) tail elongation reaction and controls also the poly(A) tail length. Increases the affinity of poly(A) polymerase for RNA. Is also present at various stages of mRNA metabolism including nucleocytoplasmic trafficking and nonsense-mediated decay (NMD) of mRNA. Cooperates with SKIP to synergistically activate E-box-mediated transcription through MYOD1 and may regulate the expression of muscle-specific genes. Binds to poly(A) and to poly(G) with high affinity. May protect the poly(A) tail from degradation. Subunit of the trimeric poly(A) tail exosome targeting (PAXT) complex, a complex that directs a subset of long and polyadenylated poly(A) RNAs for exosomal degradation. The RNA exosome is fundamental for the degradation of RNA in eukaryotic nuclei. Substrate targeting is facilitated by its cofactor MTREX, which links to RNA-binding protein adapters.
-
基因功能參考文獻:
- The expression of Ala-expanded-PABPN1 causes the formation of nuclear aggregates before the onset of muscle weakness in oculopharyngeal muscular dystrophy. PMID: 27854203
- The purpose of this study was to characterize the type of PABPN1 expanded alleles in a large cohort of Oculopharyngeal muscular dystrophy individuals from Mexico. PMID: 27980005
- We propose that the extensive binding of CircPABPN1 to HuR prevents HuR binding to PABPN1 mRNA and lowers PABPN1 translation, providing the first example of competition between a circRNA and its cognate mRNA for an RBP that affects translation. PMID: 28080204
- Whereas PABPN1 strongly increases the activity of its cognate poly(A) polymerase in vitro, Pab2 was unable to stimulate Pla1 to any significant extent. PMID: 28096519
- The described is the mRNA degradation poly(A) tail exosome targeting (PAXT) connection, which comprises the ZFC3H1 Zn-knuckle protein as a central link between MTR4 and the nuclear poly(A)-binding protein PABPN1. PMID: 27871484
- PABPN1 aggregates are able to trap TNNT3 pre-mRNA, driving it outside nuclear speckles, leading to an altered SC35-mediated splicing. PMID: 27507886
- The levels of these 6 cytokines were not altered in expPABPN1 carriers at a pre-symptomatic stage, suggesting that this group of cytokines is a potential biomarker for muscle weakness in OPMD. Correlation pattern of expression levels could be a novel measurer for disease state PMID: 27506982
- Large cohort study demonstrated that in heterozygous and homozygous patients with oculopharyngeal muscular dystrophy, the mean age at diagnosis and the severity of the clinical symptoms correlate to the number of PABPN1 (GCN) repeats. Homozygous patients showed the worse phenotype, suggesting a gene-dose effect in addition to the repeat number expansion. PMID: 28011929
- we found a polyadenylation-dependent 3' end maturation pathway for the human telomerase RNA that relies on the nuclear poly(A)-binding protein PABPN1 and the poly(A)-specific RNase PARN. PMID: 26628368
- Many ribozymes were assayed and validated, including four ribozymes targeting the transcript of a disease-causing gene (a mutant version of PABPN1). PMID: 26527730
- Studied if the stability of the RNP domain of PABPN1 or domain swapping within the RNP domain may add to fibril formation. PMID: 26267866
- This function is mediated by the concerted actions of the nuclear poly(A) binding protein PABPN1, poly(A) polymerase (PAP), and the nuclear exosome complex, a pathway we have named PABPN1 and PAP-mediated RNA decay (PPD) PMID: 26484760
- These findings demonstrate a role for PABPN1 in rescuing several cytopathological features of TDP-43 proteinopathy by increasing the turnover of pathologic proteins. PMID: 26130692
- PABPN1 inhibits expression of transcripts with pAs near the transcription start site (TSS), a property possibly related to its role in RNA degradation PMID: 25906188
- this study provided a systematic phosphorylation analysis of the Fanconi anemia protein PALB2, and have revealed important roles of PALB2 Ser-157 and Ser-376 in driving cellular responses to genotoxic stress. PMID: 26420486
- the first step of the cleavage and polyadenylation reaction, mRNA cleavage, is affected in muscles expressing alanine-expanded PABPN1. We propose that impaired cleavage is an early defect in Oculopharyngeal muscular dystrophy. PMID: 25816335
- Data indicate that intron 6 of the poly(A)-binding protein nuclear 1 (PABPN1) gene is required for autoregulation. PMID: 25963658
- The ability of PABPN1 to promote splicing requires its RNA binding and, to a lesser extent, poly(A)polymerase (PAP) - stimulatory functions. PMID: 25896913
- We show that ARIH2 E3-ligase regulates PABPN1 protein accumulation and aggregation PMID: 24486325
- Loss of PABPN1, a suppressor of APA, might promote tumor aggressiveness by releasing the cancer cells from microRNA-mediated gene regulation. PMID: 24975429
- These results suggest that PABPN1 levels regulate muscle cell aging and oculopharyngeal muscular dystrophy represents an accelerated muscle aging disorder. PMID: 23793615
- although function of PABPN1 may be compensated by nuclear translocation of PABP4 and perhaps by increase the cytoplasmic abundance of PABP5, these were not sufficient to prevent apoptosis of cells. PABPN1 may have an anti apoptotic role in mammalian cells PMID: 23300856
- Concerning the frequency of the expanded (GCN)11 polymorphism in PABPN1, all 34 patients have the normal allele, correlating genotypic and phenotypic features. PMID: 22231868
- we show that PABPN1 promotes lncRNA turnover via a polyadenylation-dependent mechanism PMID: 23166521
- Time-lapse experiments in cultured myoblasts confirm nuclear speckles as biogenesis sites of PABPN1 inclusions in oculopharyngeal muscular dystrophy. PMID: 22249111
- PABPN1 with a 17 alanine expansion generates stress that initiates apoptosis through a p53-dependent mechanism. PMID: 22519734
- Taken together, the present data suggest that heterozygote OPMD patients may show some cognitive impairments and psychological disorders PMID: 21956377
- Fibrillar PABPN1 has a structure that differs from native PABPN1 and circumstantial evidence is presented that the C-terminal domain is involved in fibril formation. PMID: 22570486
- Results elucidate a novel function for PABPN1 as a suppressor of alternative cleavage and polyadenylation. PMID: 22502866
- In myotubes, the ratio of soluble/insoluble expPABPN1 is significantly lower compared with that of the WT protein. PMID: 21854744
- Transportin binding might delay methylation of PABPN1 until after nuclear import. PMID: 21808065
- A GCG expansion (GCG)11 in polyadenylate-binding protein nuclear 1 gene caused oculopharyngeal muscular dystrophy in a Chinese family. PMID: 21647273
- no correlation was found between muscle weakness, the frequency of repeats in the polyadenine binding protein nuclear , and the frequency and size of nuclear inclusions PMID: 21545772
- The autosomal dominant form of this disease is caused by short expansions of a (GCG)(6) repeat to (GCG)(8-13) in the PABPN1 gene. PMID: 11689481
- In COS-7 cells, predominantly nuclear protein hnRNP A1 and A/B co-localize with mPABPN1 in insoluble intranuclear aggregates. PMID: 12945950
- All families carrying the mutation (GCG)(11)(GCA)(3)(GCG) shared a common ancestral haplotype and the age of the mutation was estimated in 37-53 generations by a composite likelihood method. PMID: 15694141
- a 64 year old Chinese-Malaysian woman who presented with progressive dysphagia and bilateral ptosis for about 6 years. and showed repeat expansion in one allele to (GCG)9 while normal in the other (GCG)6. PMID: 15725589
- Expanded PABPN1, presumably via the toxic effects of its polyalanine tract, leads to inclusion formation and neurodegeneration in both the transgenic mouse and the human. PMID: 15755680
- Cytoplasmic targeting of mutant PABPN1 suppresses protein aggregation and toxicity in oculopharyngeal muscular dystrophy. PMID: 16101680
- Recruitment of HSP70 and HSC70 into the cell nucleus reduced mutant PABPN1 aggregation in a HeLa cell culture model. PMID: 16239242
- PABPN1 has a role in myogenesis PMID: 16378590
- Overexpression of either the wild type or mutant PABPN1 slowed down cell proliferation. The slowing down of proliferation together with the occasional occurrence of apoptosis could contribute in vivo to the late onset of this disease. PMID: 16860991
- Mutation of the PABPN1 in oculopharyngeal muscular dystrophy (OPMD) provokes premature senescence in dividing myoblasts, that may be due to intranuclear toxic aggregates. PMID: 17005403
- the N-terminal domain of PABPN1 has a role in oculopharyngeal muscular dystrophy PMID: 17229142
- This is the first report directly indicating that nuclear aggregation in OPMD may reflect an active process by which cells sequester and inactivate the soluble toxic form of expPABPN1. PMID: 17418585
- An Italy case of oculopharyngeal muscular dystrophy in PABNPN1 mutation. PMID: 18175083
- Wild-type PABPN1 over-expression can reduce mutant PABPN1 toxicity in both cell and mouse models of Oculopharyngeal muscular dystrophy. PMID: 18178579
- We report a unique PABPN1 gene mutation in a large Bulgarian family with OPMD. PMID: 18274805
- Expression of additional HSPs including HSP27, HSP40, and HSP105 were induced in mutant PABPN1 expressing cells following exposure to the chemicals mentioned above. PMID: 18343218
- PABPN1 transgenic nematodes show muscle cell degeneration and abnormal motility. PMID: 18397876
顯示更多
收起更多
-
相關疾病:Oculopharyngeal muscular dystrophy (OPMD)
-
亞細胞定位:Nucleus. Cytoplasm. Nucleus speckle.
-
組織特異性:Ubiquitous.
-
數據庫鏈接:
Most popular with customers
-
-
Phospho-YAP1 (S127) Recombinant Monoclonal Antibody
Applications: ELISA, WB, IHC
Species Reactivity: Human
-
-
-
-
-
-